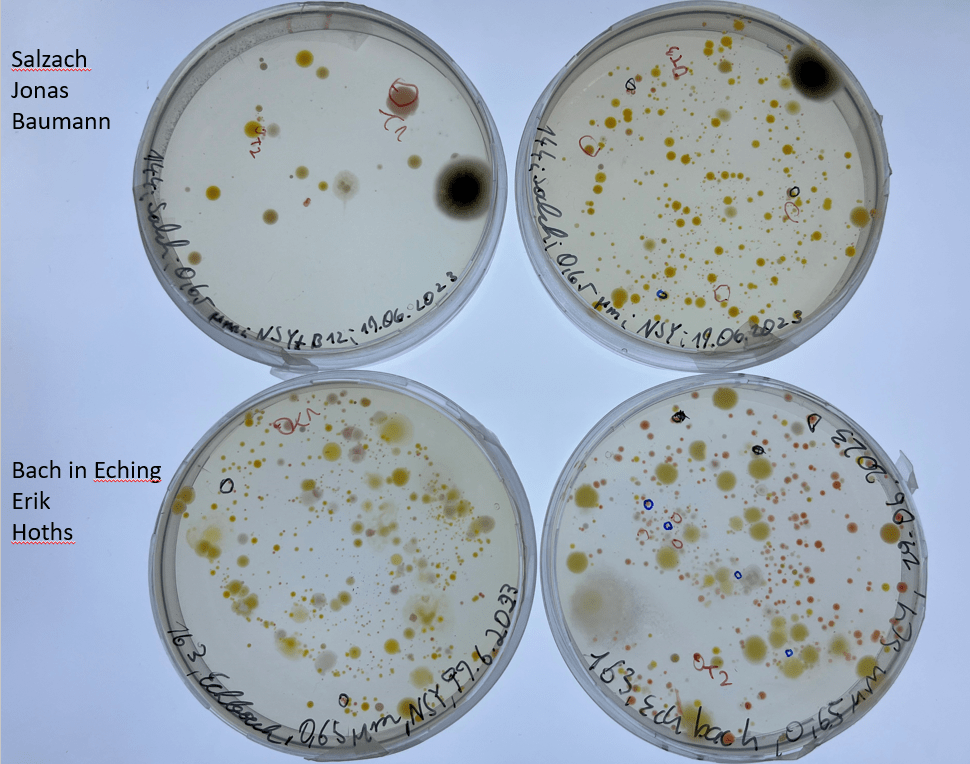
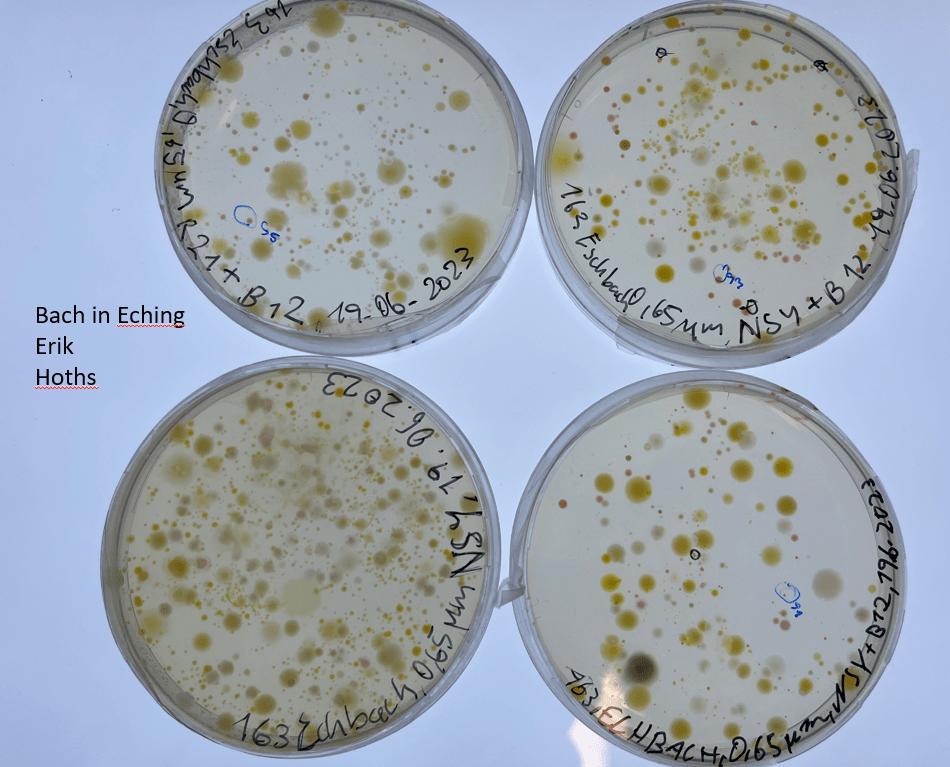
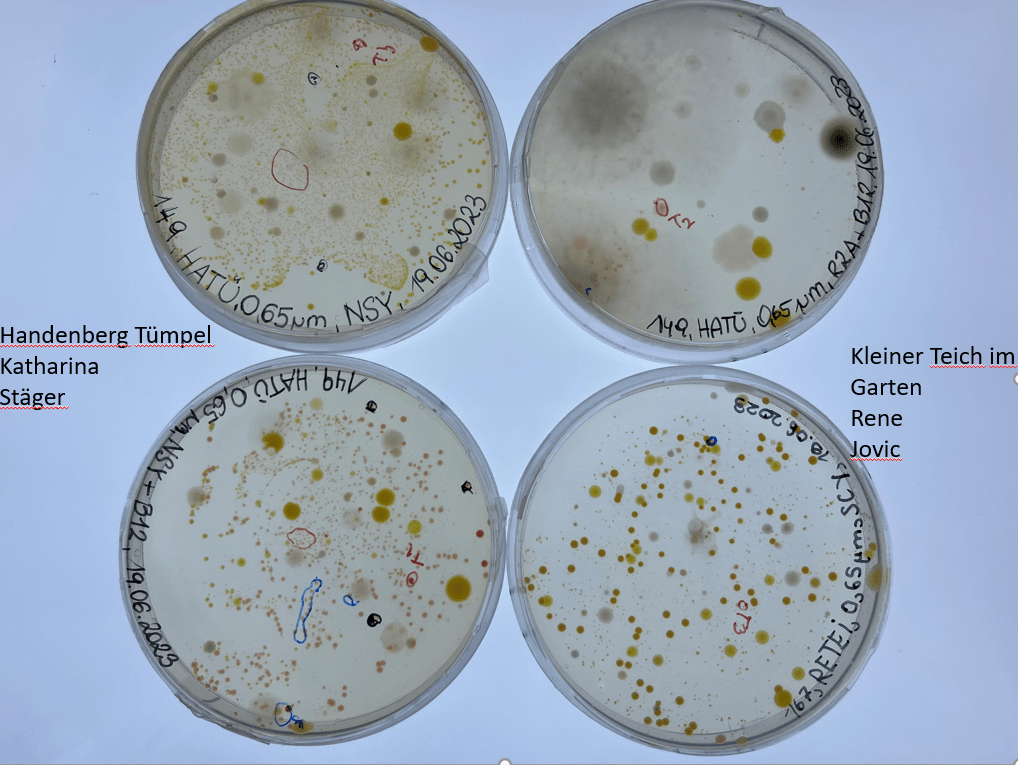
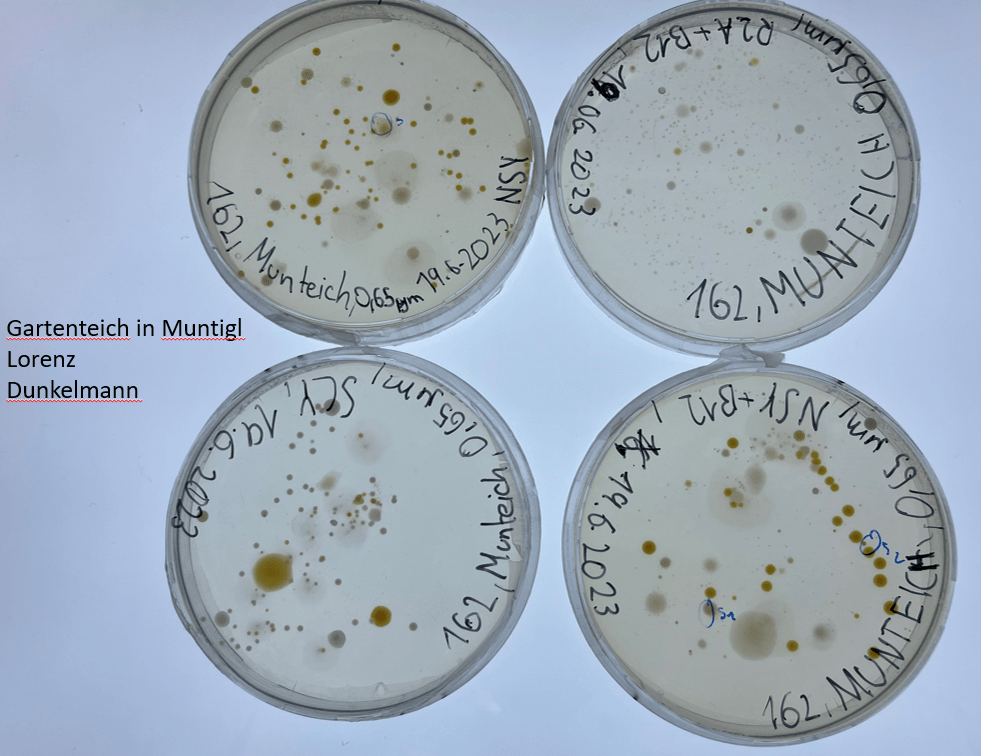
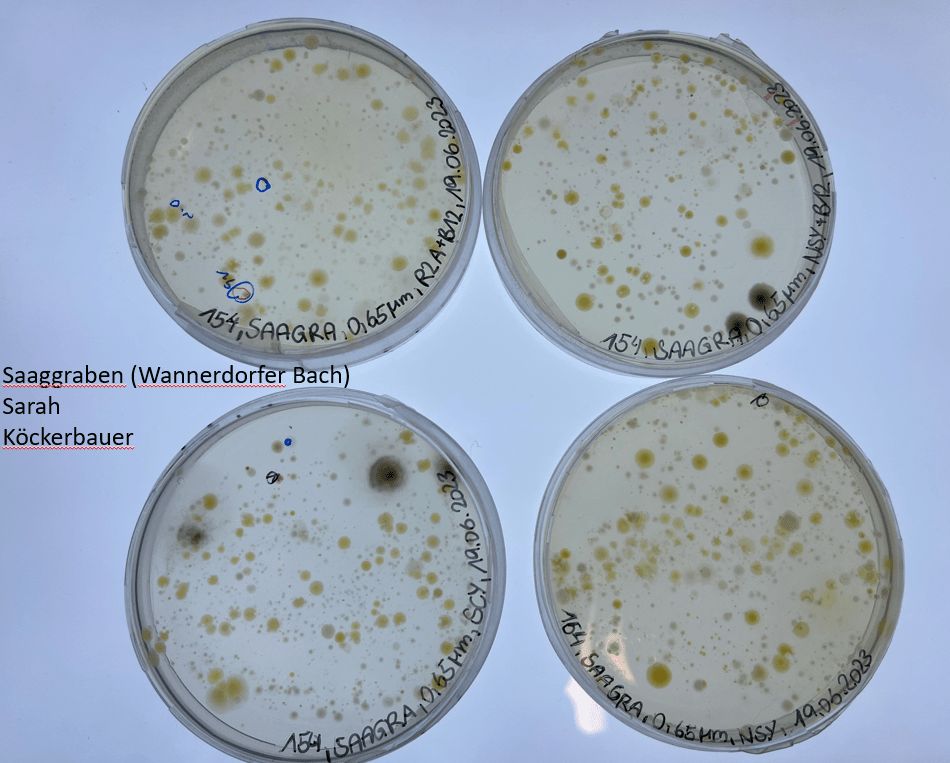

Klasse 5oN (2022/2023) mit Manuela Mascher

1. Workshop
Am 12.06.2023 waren Alexandra, Stefan und zwei Praktikanten aus der HBLA Ursprung (Tobias und Sophia) am BORG Oberndorf in der Klasse 5oN zu Besuch. zum ganzen Beitrag

2. Workshop

Am Montag den 19.06 besuchten wir (Alexandra, Stefan, Sophia und Tobias) das BORG Oberndorf ein erneutes Mal für die zweite Runde der Workshops. zum ganzen Beitrag
3. Die Gewässerproben
Hier sind Fotos von der von den Schüler/innen mit ihren gesammelten Wasserproben beimpften Agarplatten. Auf manchen Platten haben wir schon interessante Kolonien entdecken können, man erkennt sie an den Markierungen auf dem Boden der Agarplatten. Zum Teil haben uns die Pilzsporen aus der Luft etwas dazwischengefunkt, aber es sind auch viele Platten nicht kontaminiert. Ein Lob an die Schüler/innen, die sich sehr bemüht haben die Deckel nur ganz kurz anzuheben, so dass möglichst wenig aus der Luft darauf fallen konnte. Vielen Dank an unsere Sommerpraktikantin Sophia von der HBLA fürs Fotographieren und Beschriften.
4. Der Weg zu den Aquirufa Kulturen
Von den Agarplatten haben wir uns die Kolonien rausgesucht, die das typische ‚Aquirufa-Rot‘ zeigen. Diese haben wir vorsichtig mit einem (sterilisierten 😉 ) Zahnstocher in flüssiges Medium gegeben (Platte links). Dort konnten sich die Bakterienzellen weiter vermehren. Wenn die Kultur das typische Rot aufwies, haben wir davon wieder ein wenig auf eine Agarplatte pipettiert und mit einer Impföse (das sind die langen Stäbe im Bild) verteilt.

Im Bild sieht man die Flüssigkulturen. Sie stehen auf einem Schüttler in kleinen Erlenmeyerkolben und werden leicht geschaukelt, damit die Bakterien genug Luft bzw. Sauerstoff zur Verfügung haben. Inzwischen haben wir eine ganze Menge davon und müssen aufpassen, dass wir noch den Überblick behalten 😉 .

Und so sieht unser Fach im Kasten mit den Kulturen auf Agarplatten aus. Es sind ebenfalls eine ganze Menge. Zur Aufreinigung wird jeweils eine Kolonie aus einer Agarplatte ausgestochen und in flüssiges Medium gegeben. Das wiederholt man vier Mal, um eine Reinkultur, also eine Bakterienkultur, die nur Zellen von einem einzigen Bakterienstamm enthält, zu bekommen.

Um zu erfahren, ob die erhaltenen Bakterienstämme wirklich zur Gattung Aquirufa gehören, wird ein kleiner Abschnitt der DNA sequenziert. Dazu machen wir erst eine PCR und schicken das erhaltene Material zu Eurofins nach Deutschland.

Inzwischen haben wir aus sieben Gewässern von den Wasserproben des BORG Oberndorf Bakterienkulturen, die zur Gattung Aquirufa gehören. Diese große Zahl hat uns doch sehr überrascht, da nicht sehr viele Schüler/innen eine Wasserprobe dabei hatten, genauer gesagt gab es nur 10 Proben 😉 . Außerdem hatten wir mit Schimmelkolonien auf den Platten zu kämpfen, die sich selbst bei kurzzeitigem Öffnen der Petrischalen nicht ganz vermeiden lassen. Es kann sogar gut sein, dass die Klasse eine neue Art entdeckt hat, aber das wissen wir erst sicher, wenn wir von den erhaltenen Kulturen das gesamte Genom sequenziert haben.
Und das sind die Gewässer, aus denen wir bis jetzt Aquirufa-Kulturen erhalten haben: Teich in Webersdorf (TEIWEDO-141, Elena Lackner), Pladenbach (PLAD-142, Lena Mayrhofer, Laura Gaisböck), Salzach (SALCH-144, Jonas Baumann), Handenberg Tümpel (HATUE-149, Katharina Stöger), kleiner Bach bei Bürmoos (BACHBUER-151, Naomi Mota Shimabukuro), Saaggraben (Wannerdorfer Bach) (SAAGRA-154, Sarah Köckerbauer), Bach in Eching (ECHBACH-163, Erik Koths).
5. Bioinformatik Workshop
Am 6.3.2024 waren wir (Alexandra und Stefan) beim letzten Bioinformatik Workshop und zwar im BORG Oberndorf in der 6. Klasse des NAWI Zweiges mit ihrer Lehrerin Manuela Mascher zu Gast. Auch hier haben die Schüler/innen die Daten zu den aus ihren Wasserproben gewonnenen Aquirufa Bakterienstämmen ausgewertet. Aus folgenden Gewässern konnten wir gemeinsam Kulturen gewinnen: Teich in Webersdorf von Elena Lackner, Pladenbach von Lena Mayrhofer unterstützt von Laura Gaisböck, Salzach von Jonas Baumann, Handenberg Tümpel von Katharina Stöger, Bach bei Bürmoos von Naomi Mora Shimabukuro, Saaggraben von Sarah Köckerbauer und dem Eschbach von Erik Koths. Das ist wirklich ein tolles Ergebnis, zumal damals nur 10 Proben vorhanden waren. Wir haben also aus 70 % der Wasserproben unsere Aquirufas isolieren können. Aber das beste war natürlich, dass auch eine neue, noch unbekannte Art dabei ist 😊. Aus welchem Gewässer wird noch nicht verraten 😎. Wir sind gespannt auf den Artnamen, den sich die Klasse ausdenken wird. Vielen lieben Dank an die Klasse für die Mitarbeit. Übrigens ist jede einzelne Wasserprobe wichtig für uns, auch die aus der wir keine Bakterien isolieren konnten. Nur durch die große Anzahl der Wasserproben und das Mithelfen von inzwischen über 150 Schüler/innen und weiteren Citizen Scientists ist das Projekt so erfolgreich!
6. Artnamensuche
Die Klasse hat sich an der Art Namensgebung versucht. Da der als Art zu beschreibende Bakterienstamm aus dem Pladenbach in Eching stammt, haben sie sich für Aquirufa echingensis entschieden. Ein sehr schöner Name und laut unserem Kooperationspartner und Experten Aharon Oren (Mikrobiologe in Jerusalem) auch grammatikalisch korrekt. Jetzt wartet auf uns viel Arbeit beim Verfassen der Publikationen, aber das macht auch Spaß. Wir freuen uns auf ein Wiedersehen im Herbst 😊.

7. Wissenschaftliche Publikation erschienen
Unsere 3. wissenschaftliche Publikation ist erschienen und hier online verfügbar. Ca. 130 Citizen Scientist haben dabei mitgewirkt. Sechs Schulklassen und weitere Citizen Scientists haben Wasserproben aus selbst gewählten Gewässern genommen…hier gehts zum Beitrag

8. Besuch am Forschungsinstitut in Mondsee
Im März 2025 war die Klasse bei uns zu Besuch im Forschungsinstitut in Mondsee. Inzwischen sind die Schüler/innen in der 7. Klassenstufe. Wir liesen die Mitarbeit der Klasse noch einmal Revue passieren, wir hatte ja aus ihren Wasserproben eine ganze Reihe an Aquirufa Kulturen gewinnen können, auch eine neu entdeckte Art war dabei. An verschiedenen Stationen wurde das Institut erkundet. Mit dem Plaktonnetz wurde aus dem Mondsee eine Probe geholt und unter dem Mikroskop angeschaut. Wir wollten zeigen, dass im Mondsee nicht nur Bakterien leben ;-). Im Labor wurde mit Aquirufa Kulturen auf Agarplatten gemalt, die tollen Ergebnisse kann man unten betrachten. Zum Schluss gab es noch eine Jause und die Klasse schloss ihren Besuch mit einem Spaziergang zur Seepromenade ab. Wir bedanken uns ganz herzlich für die Mitarbeit und halten die Klasse über weitere Forschungsergebnisse auf dem Laufenden.